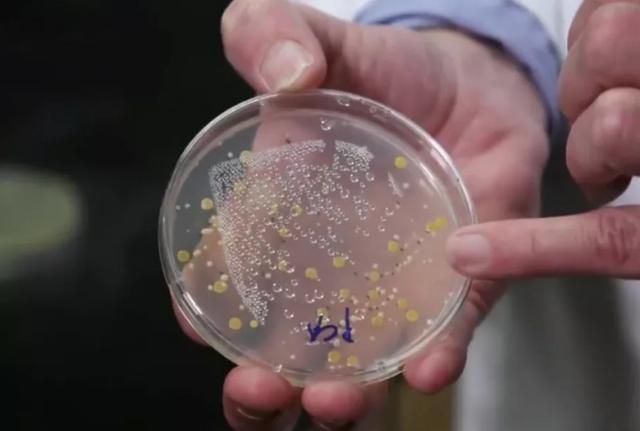
什么牌子的化妆品比马桶脏,专柜买的化妆品有质量问题能退吗

在这里先问大家一个问题:去美妆店买化妆品的时候,有用过柜台的试用化妆品吗?我敢说90%以上的女生都试过!不像衣服鞋子,美妆产品光看图片也不知道自己适不适合,毕竟口红粉底要上脸了才知道好不好看。但是你没有想过,这些不止你一个人用过的化妆品它有多脏!看完这篇文章,相信你再也不敢用这些试用装了~

前不久,加拿大广播公司(CBC)对这些试用的化妆品做了调查,得出的结果就是:我们一直信赖的试用品里,很有可能沾有别人粪便里的细菌!你没看错,这里面居然有粪便残留,到底怎么回事?

节目暗访了当地的品牌连锁店,包括MAC、丝芙兰这些大品牌连锁店,将他们在店里收集的试用品拿去做检验,检测结果显示——几乎每个化妆品样本中都含有不同种类的细菌!大多数都含有金黄色葡萄球菌,有一部分甚至已经形成了霉菌,大肠杆菌、单纯疱疹病毒、链球菌等,不懂这些专业名词没关系,时光会大概说说这些细菌。
「大肠杆菌」通常寄居在人的肠道里,通过粪便排出体外,简单点说就是粪便,这意味着有人方便后没洗手就伸向了试用品。

「单纯疱疹病毒」的感染会让人口唇生疮;「金黄色葡萄球菌」也是世界第二大能致感染的病原菌,它会引起局部化脓感染,也可引起湿疹、毛囊炎等皮肤问题。一旦感染这些病毒,出现的问题是不可逆转的,会对皮肤产生永久性的危害。
讲一个真实的案例:↓

一位美国的姑娘艾莲娜因为两年前去了一趟Sephora(开化妆品连锁超市),试用了店里的口红,接连试了几种色号,令人意想不到的是,自那几天之后她的嘴唇开始溃烂,经诊断,她是在使用Sephora的口红试用装后,感染了口腔疱疹。

这种疱疹病毒,一旦感染了就无法彻底治愈,抵抗力或免疫力不足时就很容易发病。之后艾莲娜的疱疹一直没有痊愈过,不仅不能再涂心爱的口红,还差点毁容……给她留下了一辈子的阴影。

有人会问店里的柜姐不都会定时清洁试用品吗?确实一些大品牌的店里有此项要求,但是事实确实这样的,柜姐原话:「因为种类太多了。有很多人进店给自己化一套整妆,你不可能一直盯着她们。我们会在他们试用的时候,试着清理一下化妆刷或者试用品,但是坚持做下去还挺难的」

甚至一些小的美妆精品店柜姐是这样说的:「我在启康和美妆精品店上班时,并不会去清理试用品。我们做的唯一的清洁,也就是打扫卫生、清洁一下放香水的柜台,不会专门清理化妆品。」

回想起自己之前在美妆店化妆的经历,此时不少人心躁难平……因为试用装常常摆放在柜台灯光下,受灯光近距离照射,温度较高。每天都有不计其数的消费者接触,感染大量细菌的同时,还为细菌提供了极好的繁殖条件。

一般的专柜都有专门的柜姐用一次性棉签给顾客试用,这看起来卫生。前面说的,不可避免肯定会有顾客直接接触,而且这些试用装放了3、4年之久,涂上脸简直就是在涂细菌。但是试色这个流程也非常重要,下面时光给你一些试用化妆品的小建议:
1、不要上脸!能用手试就尽量用手,试完抓紧擦掉
2、不要入嘴!不管看上去多干净都不行
3、不要使用公共化妆刷!向柜姐索要一次性化妆刷试用
4、不要去使用别人直接上手触碰过的化妆品
5、尽量选择压泵式试用品,避免手指蘸取式
6、试用之前最好用含有酒精的清洁剂清洁一遍
谢谢你的阅读,喜欢时光的可以关注和点赞哦,你的支持会是我努力的方向。
本文由原创,图片为转载,如有侵权,请联系删除,未经允许,拒绝任何转载